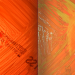

IMPORTANCE
The main goal of every sheep and goat farm is to produce meat and/or milk, which is why healthy parturition is essential and considered the most important part of the animal’s productive cycle.
“Economic impact: loss of lambs/kids, milk and cost of feeding until the next parturition”
After an abortion, the animal starts an unproductive period lasting a minimum of 7 months. This has a huge economic impact on the farm due to the loss of the expected product (lamb and/or milk) in addition to the cost of maintaining (feeding) the affected animals.
DIAGNOSIS
Acting quickly allows a considerable reduction of farm losses.
The first step is to determine the cause of the abortions: non-infectious or infectious. Laboratory diagnosis is always needed to confirm or rule out the presence of infectious pathogens.
PREVENTION MEASURES
If an abortion occurs, certain management measures must be applied even before the cause is known (isolation of the aborted animal, disposal of the placenta and foetus, disinfection of the delivery area, etc.).

“If an infectious abortion is suspected, laboratory diagnosis is mandatory”
In case of infectious abortion, once the cause has been confirmed, appropriate and specific control and prevention measures must be established (hygiene, biosecurity, vaccination, etc.). Confirmation of this type of abortion always requires confirmation by a diagnostic lab (history-taking and clinical signs are not sufficient).